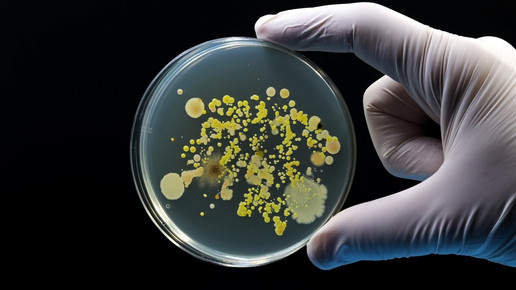
Studie: Antibiotika werden nicht adäquat verordnet

Studie: Antibiotika werden nicht adäquat verordnet
An nicht-universitären Krankenhäusern in Deutschland werden häufig Antibiotika verschrieben, die nicht den empfohlenen Qualitätsstandards entsprechen. Dies zeigte eine gestern erschienene Studie des Universitätsklinikums Freiburg. Im Hinblick auf die sich verstärkenden Resistenzen bestehe dringend Handlungsbedarf, so der Studienleiter.
Eine Untersuchung an zehn unterschiedlich großen Krankenhäusern in Baden-Württemberg hat belegt, dass es einen dringenden Optimierungsbedarf bei der Antibiotika-Auswahl gibt. Die nun erschienene Studie des Universitätsklinikums Freiburg zeigt: Es gibt deutliche Defizite bei der Antibiotikaverordnung in nicht-universitären Krankenhäusern in Deutschland. Die Ergebnisse wurden im Fachmagazin „Eurosurveillance“ veröffentlicht.
Hierfür wurden im Jahr 2021 über 8500 Patient:innen untersucht. Das Ergebnis ist ernüchternd: Die Verschreibungen von antibiotischen Medikamenten entsprechen häufig nicht den empfohlenen Qualitätsstandards. „Unsere Ergebnisse verdeutlichen den dringenden Bedarf an nachhaltigen Antibiotikaprogrammen und an Fachärzt:innen für Infektiologie, um die Versorgung der Patient:innen zu verbessern“, erklärt Studienleiter Dr. Siegbert Rieg, Leiter der Abteilung Infektiologie der Klinik für Innere Medizin II des Universitätsklinikums Freiburg. „Nur so können wir langfristig Resistenzen vorbeugen und die Behandlungsqualität steigern.“
Antibiotika nicht angemessen eingesetzt
Von den untersuchten Proband:innen erhielt etwa ein Drittel mindestens ein Antibiotikum. Dies wurde meist zur Therapie eingesetzt, aber in selteneren Fällen auch zur Prävention. Insgesamt gab es eine große Streuung der Verordnungsqualität. Bei einem Viertel der Therapien wurde nicht adäquat verordnet. Mehr noch: Bei etwa der Hälfte der Patient:innen hätten Antibiotika mit schmalerem Wirkspektrum verordnet werden können.
Auch auf weitere Qualitätsindikatoren wie die rechtzeitige Dokumentation der Behandlungsdauer oder die Überprüfung der Antibiotikatherapie nach einem kurzen Zeitraum wurden nur in circa einem Drittel der Fälle geachtet. Eine Umstellung von intravenösen auf orale Antibiotika sei zudem auch zu selten erfolgt, so die Studienautor:innen. Diese habe nur bei etwa der Hälfte der Patient:innen stattgefunden, bei denen das eigentlich sinnvoll gewesen wäre.
„Defizite tragen zu Resistenzen bei“
Ebenso kritisch: Nur in 45 Prozent der Fälle erfolgte eine Blutkulturanalyse und bei nur etwa 60 Prozent der Patient:innen wurden ausreichende mikrobiologische Proben vor Beginn der Antibiotikatherapie entnommen. Diese Untersuchungen liefern jedoch wesentliche Erkenntnisse zur Therapiesteuerung. „Neben optimierungsbedürftiger Antibiotika-Auswahl beeinträchtigen fehlende Diagnostik und mangelhafte Dokumentation die Qualität der Versorgung erheblich. Diese Defizite gefährden nicht nur die Wirksamkeit der Behandlung, sondern tragen auch zur Entstehung von Resistenzen bei“, betont Rieg.
Die Studie verdeutlicht den Bedarf an strukturierten Programmen, die für eine sachgemäße Verschreibung und Anwendung von Antibiotika sorgen, so die Forschenden. „Solche Antimicrobial Stewardship-Programme könnten erheblich dazu beitragen, unnötige Antibiotikatherapien zu reduzieren und die Qualität der Behandlungen zu erhöhen“, so Rieg. Derzeit würden solche Programme und spezialisiertes Fachpersonal in Form von Fachärzt:innen für Innere Medizin und Infektiologie in den meisten nicht-universitären Krankenhäusern jedoch fehlen.
„Mit dem Wissen, das seit mehr als 15 Jahren an unserer Klinik zu Antibiotic Stewardship und zum infektiologischen Konsiliarservice aufgebaut wurde, können wir anderen Krankenhäusern eine wichtige Unterstützung bieten. Dass diese erforderlich ist, zeigen unsere Befunde“, so Dr. Robert Thimme, Ärztlicher Direktor der Klinik für Innere Medizin II des Universitätsklinikums Freiburg.
„Deutschland hat Nachholbedarf“
„Ein flächendeckender Einsatz von Antimicrobial Stewardship und die breite Verfügbarkeit spezialisierter Infektiolog:innen sind entscheidende Maßnahmen, um die Versorgungsqualität zu verbessern. Deutschland hat hier Nachholbedarf“, so Rieg. Und weiter: „Weitere Untersuchungen sollen nun im Rahmen der ID-Roll-out-Studie zeigen, wie die Einführung von AMS-Programmen genau strukturiert sein sollte und wieviel spezialisiertes Personal erforderlich ist, um den größtmöglichen Effekt auf die Qualität der Antibiotikatherapie in nicht-universitären Krankenhäusern zu erzielen.“

APOTHEKE ADHOC Debatte